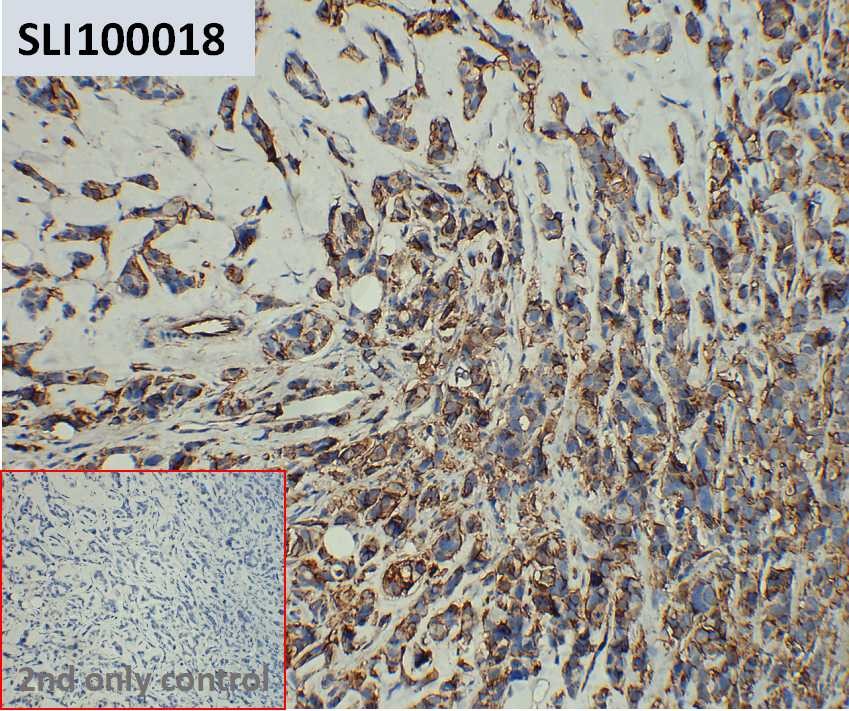

| Target | |
|---|---|
| Description | The embedded and sliced tumor sections (4μm section) from M-NSG mice implanted with MCF-7 cells |
| Host Cells | MCF-7 |
| Applications | IHC |
| Host mice | M-NSG |
| Delivery | 1 week |
| Guarantee | 36 months from the date of manufacture |
| Background | These carefully prepared tissue slides offer researchers standardized and high-quality samples for antibody testing. Utilizing tumor models derived from immunocompromised mice, researchers can confidently assess antibody specificity and sensitivity, driving advancements in cancer diagnostics and therapeutics. |
| Storage & Shipping | Room temperature |
| Usage | Research use only |
服務(wù)熱線
400-006-0995
18062749453